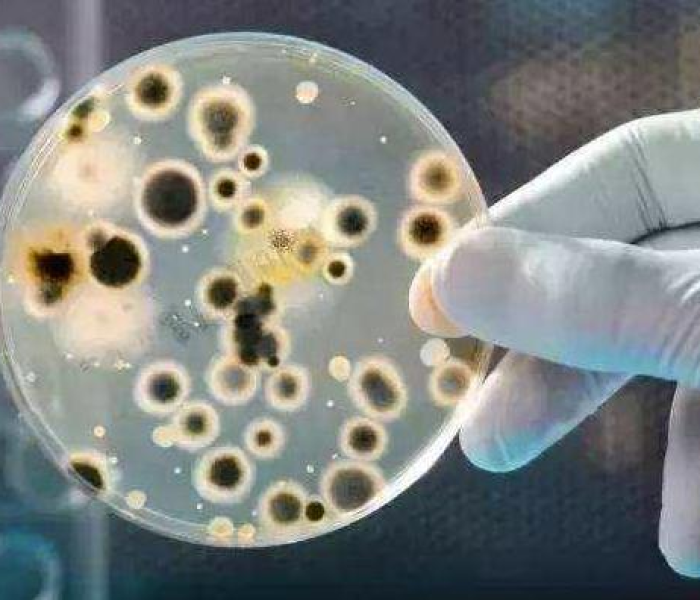
海里发现新冠病毒/海里发现新冠病毒了吗

一项突破性研究显示,科学家在全球多个海域的海水样本中检测到了新冠病毒的踪迹,这一发现迅速引发全球关注,不仅因为新冠病毒主要通过飞沫和接触传播,更因为它可能暗示着病毒在环境中的潜在传播途径,海水作为地球上最广泛的水体,其污染问题本就严峻,如今病毒的出现,无疑为公共卫生和生态安全敲响了警钟,本文将深入探讨这一现象的发现背景、科学依据、潜在影响及应对策略,旨在为公众提供全面而独特的解读。
海里发现新冠病毒的科学研究与背景
新冠病毒(SARS-CoV-2)自2019年底暴发以来,已造成全球数亿人感染,其传播途径主要集中于呼吸道飞沫、气溶胶和接触传播,随着研究的深入,科学家开始关注病毒在环境介质中的存活能力,2023年初,一项由国际海洋研究团队主导的调查,在多个沿海城市的海水样本中,通过高灵敏度PCR技术检测到了病毒RNA片段,这些样本来自人口密集的沿岸区域,如美国东海岸、欧洲地中海沿岸及亚洲部分海域,其中一些样本还显示出病毒在特定条件下(如低温和高盐度)可能存活数小时至数天。
这一发现并非偶然,早前的研究已证实,新冠病毒可在废水中存活,并通过污水处理系统进入自然水体,海水中的病毒可能源于人类活动,如未经处理的污水排放、旅游活动或船舶废弃物,科学家指出,尽管海水中病毒的浓度较低,且目前尚无证据表明它能通过海水直接感染人类,但这一现象凸显了病毒在环境中的持久性和潜在扩散风险,在实验室模拟中,病毒在海水中的存活时间受温度、盐度和微生物活动影响,低温环境可能延长其存活期,这为极地海域等脆弱生态系统带来了额外担忧。

潜在影响:从公共卫生到生态平衡
海里发现新冠病毒,首先引发的是对公共卫生的担忧,尽管直接通过海水感染的风险较低,但病毒可能通过海洋气溶胶、海鲜污染或休闲活动(如游泳和冲浪)间接传播,如果病毒在贝类等海产品中富集,可能通过食物链威胁人类健康,历史上,诸如诺如病毒等病原体就曾通过水体传播,导致疫情暴发,新冠病毒若在海洋环境中持续存在,可能加剧全球疫情的不确定性,尤其在沿海社区和旅游业中。
从生态角度看,这一发现警示我们,人类活动对海洋的污染已超越传统范畴,海洋本是生命的摇篮,但如今成为病毒“藏身”之所,可能干扰海洋生态平衡,病毒若在海洋生物中传播,可能影响鱼类和哺乳类的健康,进而破坏食物网,海洋微塑料等污染物可能与病毒结合,形成更复杂的传播载体,长远来看,这不仅威胁生物多样性,还可能加剧气候变化下的海洋酸化问题。
科学应对与全球合作
面对这一新挑战,科学界呼吁加强监测和研究,全球需建立海洋病毒监测网络,定期检测海水样本,并评估病毒变异风险,世界卫生组织和联合国环境规划署可牵头制定指南,帮助各国规范污水处理和海岸管理,公众教育至关重要,人们应避免在疫情高发区游泳或接触可能污染的海水,同时支持可持续的海洋保护行动,如减少塑料使用和推动绿色能源。
技术上,开发高效的病毒灭活方法成为当务之急,利用紫外线消毒或纳米过滤技术处理沿岸废水,可降低病毒入海风险,跨学科合作不可或缺——海洋学家、流行病学家和环保专家需携手,探索病毒在环境中的行为模式,中国在疫情期间的废水监测经验,可为全球提供借鉴,例如通过大数据预测病毒扩散趋势。
海里发现新冠病毒,不仅是科学上的一个突破,更是一次环境警醒,它提醒我们,病毒传播已超越人际范畴,深入自然生态系统,在全球化时代,人类与海洋的命运紧密相连,唯有通过科学创新和全球协作,才能守护这片蓝色星球的健康,我们需继续关注这一领域的研究,以应对可能的新发威胁,确保人类与自然的和谐共生。
